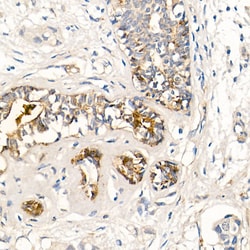
Invitrogen MMP7 Recombinant Rabbit Monoclonal Antibody (8T4R8) 100 &mu;L;

Learn More
Invitrogen™ MMP7 Recombinant Rabbit Monoclonal Antibody (8T4R8)
Rabbit Recombinant Monoclonal Antibody
Marke: Invitrogen™ MA551356
Beschreibung
Immunogen sequence: MRLTVLCAVC LLPGSLALPL PQEAGGMSEL QWEQAQDYLK RFYLYDSETK NANSLEAKLK EMQKFFGLPI TGMLNSRVIE IMQKPRCGVP DVAEYSLFPN SPKWTSKVVT YRIVSYTRDL PHITVDRLVS KALNMWGKEI PLHFRKVVWG TADIMIGFAR GAHGDSYPFD GPGNTLAHAF APGTGLGGDA HFDEDERWTD GSSLGINFLY AATHELGHSL GMGHSSDPNA VMYPTYGNGD PQNFKLSQDD IKGIQKLYGK RSNSRKK.
Proteins of the matrix metalloproteinase (MMP) family are involved in the breakdown of extracellular matrix in normal physiological processes, such as embryonic development, reproduction, and tissue remodeling, as well as in disease processes, such as arthritis and metastasis. Most MMP's are secreted as inactive proproteins which are activated when cleaved by extracellular proteinases. The enzyme encoded by this gene degrades proteoglycans, fibronectin, elastin and casein and differs from most MMP family members in that it lacks a conserved C-terminal protein domain. The enzyme is involved in wound healing, and studies in mice suggest that it regulates the activity of defensins in intestinal mucosa. The gene is part of a cluster of MMP genes which localize to chromosome 11q22. 3.
Spezifikation
| MMP7 | |
| Recombinant Monoclonal | |
| 1 mg/mL | |
| PBS with 0.05% BSA, 50% glycerol and 0.05% ProClin 300; pH 7.3 | |
| P09237 | |
| MMP7 | |
| Recombinant fusion protein containing a sequence corresponding to amino acids 1-267 of human MMP7 (P09237). | |
| 100 μL | |
| Primary | |
| Human | |
| Antibody | |
| Liquid |
| ELISA, Immunohistochemistry (Paraffin), Western Blot | |
| 8T4R8 | |
| Unconjugated | |
| MMP7 | |
| HGNC:7174; MAT; Matrilysin; matrilysin, uterine; matrin; matrix metallo protease; matrix metallopeptidase 7; matrix metallopeptidase 7 (matrilysin, uterine); matrix metalloproteinase 7; Matrix metalloproteinase 7 (matrilysin); matrix metalloproteinase 7 (matrilysin, uterine); matrix metalloproteinase-7; MMP; MMP 7; MMP7; Mmp-7; MMP-7 protein; MMPs; MPMM; MPSL1; PUMP 1; Pump 1 protease; PUMP1; PUMP-1; pump-1 protease; uterine matrilysin; uterine metalloproteinase | |
| Rabbit | |
| Affinity chromatography | |
| RUO | |
| 4316 | |
| -20°C, Avoid Freeze/Thaw Cycles | |
| Liquid | |
| IgG |
Bitte geben Sie uns Ihr Feedback zu den Produktinhalten, indem Sie das folgende Formular ausfüllen.